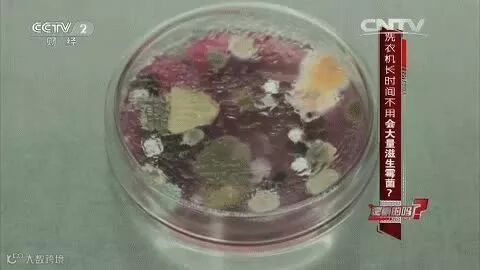

要问家用电器里,你最离不开哪个?小编会毫不犹豫地回答,洗衣机!毕竟上一天班回来,还要手洗衣服,那可是人生一大悲剧啊!大家说有木有?
不过,对不少人来说,用洗衣机洗洗外衣也就罢了,一旦说到洗内裤,就算再累,他们还是选择手洗。
那么问题来了,手洗内裤一定更好吗?

手洗PK机洗,哪个更好?
要问哪种洗法更好,且听小编一个个分析~
★ 机 洗
人们常说洗衣机比马桶还脏!(马桶:怎么什么都和我比,我不要面子的啊!)真是这样的吗?
其实,这个说法可能过于夸张了。
洗衣机里的细菌,多是我们平时能接触到的,致病菌不算很多。再加上我们的身体有免疫屏障,所以感染的概率并不大。

不过,洗衣机“细菌窝”之名也不是空穴来风。
央视《是真的吗》栏目组曾做过调查。结果发现,一周没使用的洗衣机里,每毫升的菌落数有5个,而两个月没用的洗衣机里,其菌落数不计其数。
(图片来源于网络)
菌落里的霉菌可能会引发一些皮肤疾病,如霉菌性阴道炎、龟头炎、慢性荨麻疹等。好在霉菌感染一般和免疫力有关,所以大家也不必太过担心,想机洗就机洗~
不过,机洗时必须注意:
1. 为避免洗衣机成为新的传染源,建议定期清洁、消毒洗衣机。
2. 如果女性内裤上有分泌物,男性内裤上有梦遗的蛋白分子,要先用清洁剂简单清洗,否则容易有一层生物膜附在上面,导致细菌滋生。
3. 小孩免疫力弱,他们的内裤别机洗。
虽说机洗有缺点,那么手洗一定更好吗?
★ 手 洗

先给每天坚持手洗内裤的朋友们点个赞。说实话,用手搓洗内裤确实比较干净、彻底,不过,手洗也是有缺点滴~
手洗时,多数人容易“用力过猛”,使用过多洗涤剂,如肥皂、除菌皂、洗衣粉、洗衣液等,因此,冲洗时极有可能会冲不干净。
另外,洗完内裤还可能无法完全拧干,一旦潮湿时间太长,很容易发霉。如果再碰到潮湿的回南天,那内裤发霉的几率就更大了!

因此,选手洗没问题,但要注意:
1. 手洗时,要尽量多冲几遍。
2. 女生一般分泌物较多,洗内裤时,需特别清洗重点部位。
敲黑板,总结一下:机洗、手洗内裤各有优缺点,也各有改进的方法,说不上哪个更好,所以具体选哪个,看你们自己喽~
讲真,纠结机洗是不是更好的人群,多半是懒得手洗。那么,纠结下面这个问题的,可算是懒癌晚期了~

内裤和袜子能一起洗吗?
要问内裤和袜子能不能一起洗,先得知道它们上面都有啥~
穿过的袜子上,除汗液以外,还有真菌和老旧角质等。而脚臭的人穿过的袜子上,除了以上所说的,可能还有红色毛癣菌、絮状表皮癣菌等真菌及臭味代谢物。
而内裤上,除了某些分泌物外,还可能有残留的尿液和便便。据研究显示,每条脏内裤上平均带有0.1克粪便。
要知道,一克粪便中通常含有1000万个病毒、100万个细菌、1000个寄生虫包囊和100个虫卵。
这样看来,内裤和袜子,指不定哪个更脏呢!

实际上,在没有脚部和生殖器感染的情况下,用自己的洗衣机反复搅拌、冲洗内裤袜子,可以大大避免交叉感染的可能性。
此外,清洗时使用除菌皂和消毒液,可以让大多数细菌和致病菌丧命。
即使有小部分细菌等残活下来,只要在干燥环境下及时晾干,也能抑制细菌的生长繁殖。
如果还不能完全消灭细菌,也别怕,只要人体健康、免疫力正常,也能抵抗细菌的攻击。

所以,简单来说,只要满足以下4个条件,内裤袜子是可以一起洗的~
1. 有自己的洗衣机,不用公共洗衣机
2. 无皮肤或生殖器疾病,免疫力正常
3. 袜子内裤天天换,清洗时使用消毒液
4. 能及时烘干或在干燥环境下晾干
讲真,这种内裤袜子一起洗的情况,更适合独居者。但对于家庭来说,一家人的衣物,难免会一起洗。那么问题又来了↓↓↓

能和别人的内裤一起洗吗?

医生的建议是最好单独洗。特别是碰到以下情况的,绝不能马虎:
1. 有皮肤病或其它传染病的人,其衣物要单独洗,以免把疾病传染给他人。
2. 女性的阴道口、尿道口、肛门靠得很近,病菌很容易进入阴道或尿道,引起生殖系统或泌尿系统感染。因此,女性的内裤也要单独洗。
3. 孩子免疫力弱,他们的内裤必须单独洗,以充分漂洗为宜。
由此看来,还是各洗各的吧!不过,说的容易,可是有时候真的很累,那能不能攒几条一起洗啊?

内裤一条条洗还是混在一起洗?

讲真,一条脏内裤上都有啥,不用小编再说了吧!想想那些寄生虫、虫卵之类,你还能留着它过夜吗?
万一哪天真没洗,也别和后来换下来的混在一起。内裤积一起,更容易繁衍大量细菌,彻底洗干净的难度也会更大。
所以,既然已经懒过一次了,这次就老老实实一条条好好搓洗吧~
敢不敢告诉大家
你平时都是咋洗内裤的?

编辑:阿初
大家都在看
点击图片即可阅读
老铁们,麻烦帮我单击这颗心❤↓↓




